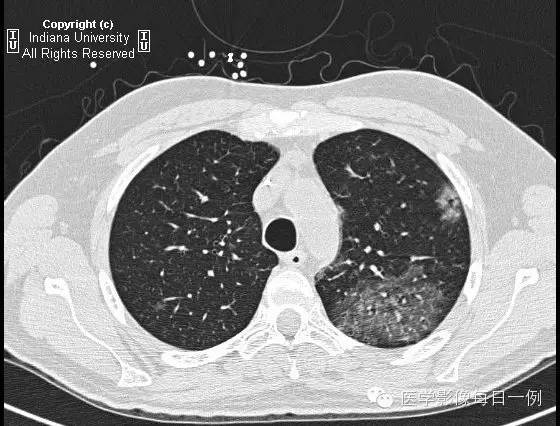
【病例】肺泡性出血1例X线 CT影像表现

【病例】肺泡性出血1例X线 CT影像表现
发布时间:2022-10-21
发布时间:2022-10-21
【病史】男性,缺氧性改变。
胸部正位片

问题1.下述哪项为此片的最佳表述?
A.张力性气胸
B.充血性心力衰竭
C.双肺基底部肺泡透光度减低
D.大量胸腔积液
E.心脏内异物
【答案】1.C注释:主要表现为双肺基底部肺泡透光度减低,边界模糊。
追加临床病史:进一步检查发现此患者患有急性粒细胞白血病并全血细胞减少。
CT检查

问题2.此患者应诊断为?
A.卡氏肺囊虫肺炎
B.侵袭性曲霉菌病
C.感染性栓塞
D.肺出血
E.药物反应
【答案】2.D注释:支气管肺泡灌洗示肺出血,无合并性感染。
【影像学改变】
胸片示双肺肺泡性病变,主要为基底部肺泡性疾病或渗出。
胸部CT示弥漫性肺泡透光度减低,主要位于右肺下叶和左肺上叶,呈铺路石样改变。胸膜无渗出。
【鉴别诊断】(铺路石征)
卡氏肺囊虫肺炎
肺水肿
肺泡蛋白沉积症
肺泡性出血
【诊断】Alveolar hemorrhage
肺泡性出血
【关键点】
【可致肺出血的病因】
上一篇:【病例】肺脓肿1例CT影像特点